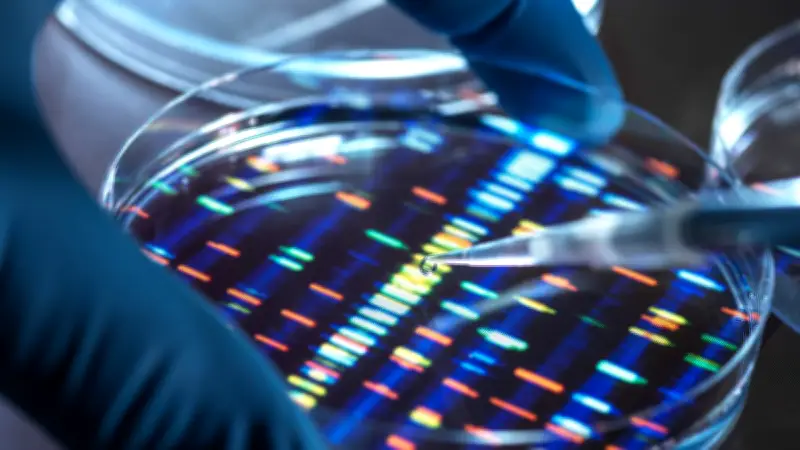
25 Jahre nach dem Genom-Durchbruch: Warum die Genetik noch viele Rätsel birgt

Grenzen der Genetik: 25 Jahre nach der Entschlüsselung des menschlichen Genoms
Die Entschlüsselung des menschlichen Genoms hat die Medizin und Forschung tiefgreifend verändert. Genetisches Wissen ermöglicht heute gezieltere Therapien bei Krankheiten wie Krebs oder Alzheimer. Doch auch nach einem Vierteljahrhundert intensiver Forschung bleiben viele grundlegende Fragen unbeantwortet.
Ein historischer Meilenstein mit dramatischem Wettlauf
Vor 25 Jahren, am 12. Februar 2001, veröffentlichten Wissenschaftler erstmals die Ergebnisse des Human Genome Projects in den Fachjournalen Science und Nature. Dieses Projekt, oft mit der Mondlandung verglichen, kartierte den genetischen Bauplan des Menschen – einen etwa 3,2 Milliarden Buchstaben umfassenden DNA-Faden auf 23 Chromosomen. Dieser unvorstellbar lange Text würde etwa 3000 Bücher füllen und bildet sozusagen die Software des Lebens.
Begonnen hatte das ehrgeizige Vorhaben am 14. September 1990 als öffentliches, vorwiegend amerikanisches Großforschungsprojekt. Schnell entwickelte es sich zu einem losen Verbund von Arbeitsgruppen aus über 30 Ländern, wobei rund 60 Prozent der Arbeit in US-Zentren stattfanden. Auch deutsche Forschungsteams waren beteiligt. Die Gesamtkosten beliefen sich auf etwa 3 Milliarden Dollar.
Doch die Einigkeit währte nicht lange. Der US-Wissenschaftler Craig Venter kündigte 1998 an, das Genom mit seiner Firma Celera Genomics im Alleingang zu entschlüsseln – mit einer schnelleren, aber nach Ansicht vieler Fachleute ungenaueren Schrotschuss-Methode. Ein harter Wettlauf um Geld und Ehre entbrannte, bei dem Celera Zugang zu den Daten der Konkurrenz hatte, während Venter seine Erkenntnisse nicht teilte.
Fortschritte und offene Lücken
Am 26. Juni 2000 verkündete Venter im Weißen Haus neben US-Präsident Bill Clinton die Entzifferung des menschlichen Genoms, allerdings nur in einer Arbeitsversion. Die wissenschaftliche Community sieht daher die Veröffentlichung vom Februar 2001 als den eigentlichen Stichtag an, da diese einen Begutachtungsprozess durchlaufen hatte.
Einige entscheidende Regionen des Erbguts, das aus den vier Nukleinbasen Cytosin, Guanin, Adenin und Thymin besteht, blieben damals unkartiert; es fehlten etwa acht Prozent. Erst 2022 schloss ein internationales Forschungskonsortium diese Lücken und gewann dabei neue Erkenntnisse.
Die Ergebnisse des Projekts waren verblüffend: Der genetische Text ist bei allen Menschen zu 99,9 Prozent identisch, und der Homo sapiens besitzt nur etwa 25.000 Gene – nur doppelt so viele wie eine Fruchtfliege. Dies wirft die Frage auf, wie sich dann die ganze Komplexität des Menschen erklären lässt.
Von der ersten Karte zur genetischen Vielfalt
Was als Entschlüsselung des Erbguts eines einzelnen Menschen begann, hat eine unglaubliche Entwicklung genommen. Heute können schnelle Computer das Erbgut jedes Menschen in wenigen Stunden auslesen. Um die Diversität der Menschheit besser darzustellen, suchen Forscher nach dem humanen Pangenom, das Erbgut aus verschiedenen Regionen und Ethnien vergleichbar machen soll. Im Mai 2023 wurde der erste Entwurf im Fachmagazin Nature veröffentlicht, basierend auf den Erbinformationen von 47 Personen. Künftig sollen Daten von 350 Personen zu diesem Referenzmodell beitragen.
Medizinische Chancen und ethische Herausforderungen
Für einige Krankheiten wie Alzheimer und Diabetes haben Forscher bereits verantwortliche Gene identifiziert, was zu gezielteren Behandlungsmöglichkeiten führte. Neue Perspektiven bieten Technologien wie die Genschere, mit der defekte Gene entfernt oder ausgetauscht werden können, sowie künstliche Intelligenz, die hilft, den Bauplan des Menschen besser zu lesen.
Dem Klimawandel angepasste Pflanzen, Nahrungsmittelsicherheit und neue medizinische Anwendungen wecken Goldgräberstimmung in Wissenschaft und Wirtschaft. Doch mit diesen Chancen gehen neue ethische Fragen einher, etwa bei der Forschung an menschlichen Embryonen.
Die vielen verschlossenen Türen der Genetik
Zugleich haben Wissenschaftler erkannt, dass die Kenntnis des Genoms bei Weitem nicht ausreicht. Die Chemikerin Friederike Fehr vom Max-Planck-Institut in Göttingen vergleicht es damit, dass eine Tür aufgeschlossen wurde, hinter der sich viele neue verschlossene Türen verbergen. Offen bleiben Fragen wie:
- Wie werden Gene reguliert?
- Welche Funktionen haben die von ihnen produzierten Proteine?
- Welche Informationen stecken zwischen den Genen, in Bereichen, die einst als Junk-DNA abgetan wurden?
US-Präsident Bill Clinton sagte im Jahr 2000: Jetzt lernen wir die Sprache, mit der Gott das Leben erschuf. Heute ist klar, dass dazu noch viele Vokabeln fehlen. Die Genetik bleibt ein faszinierendes, aber komplexes Feld mit ungelösten Rätseln.









